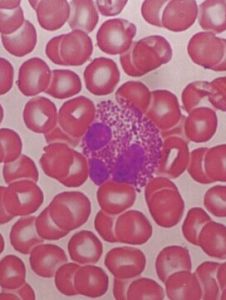
粒細胞減少症 粒細胞減少症

病因
中性粒細胞的生長在骨髓中可分為幹細胞池、分裂池、儲存池。成熟的中性粒細胞多儲存於骨髓,可隨時釋放入血。進入血液後,中性粒細胞一半附於小血管壁,稱為邊緣池,另一半在血液循環中,稱為循環池,二者之間互相交換。中性粒細胞在外周血的半衰期很短,6~7小時,隨後進入組織。中性粒細胞減少原因很多,發病機制複雜,臨床上分為三類:
1.中性粒細胞生成缺陷
(1)細胞毒藥物、化學毒物和輻射:是最常見的原因。
(2)感染與異常免疫:一些細菌、病毒、立克次體或原蟲感染。
(3)骨髓異常細胞成分浸潤:白血病、淋巴瘤骨髓侵犯、轉移癌等。
(4)骨髓衰竭性疾病:再生障礙性貧血、陣發性睡眠性血紅蛋白尿症等。
(5)多種先天性中性粒細胞減少症:具體機制不明。
(6)中性粒細胞成熟障礙:葉酸、維生素B缺乏、骨髓增生異常綜合徵等。
2.中性粒細胞破壞或消耗過多
(1)免疫性因素各種自身免疫性疾病、某些感染如慢性肝炎。
(2)非免疫性因素嚴重細菌感染、敗血症、病毒感染或脾功能亢進。
3.中性粒細胞分布異常
某些異體蛋白反應、內毒素血症可引起中性粒細胞轉移至邊緣池,脾大時,粒細胞滯留於脾。
診斷
1.常有感染、理化物質接觸、用藥、免疫因素等病史。
2.粒細胞缺乏時,起病急驟,可出現重症感染症狀。
3.血常規:白細胞數減少,中性粒細胞減少,淋巴細胞比率相對增多。根據中性粒細胞減少的程度可分為輕度(≥1.0×10 /L)、中度(0.5~1.0×10 /L)、重度(<0.5×10 /L)
(4)骨髓象:無特異性變化。
治療
1.病因治療
明確病因,積極治療原發病。若由藥物引起,需停用可疑藥物如抗生素、退熱止疼藥等。
2.防治感染
輕度粒細胞減少,不需特別的預防措施,中度減少者,感染幾率增加,減少進出公共場所,注意皮膚、口腔、呼吸道衛生,去除慢性感染灶。粒細胞缺乏者,應採取隔離措施,防止交叉感染。有感染者,進行病原菌培養,明確感染部位和類型。在致病菌未明確前,應經驗性採用廣譜、高效、足量抗生素治療,注意真菌感染。
3.對症、升白治療
可套用鯊肝醇、利血生,粒細胞缺乏者,可予粒細胞集落刺激因子治療。